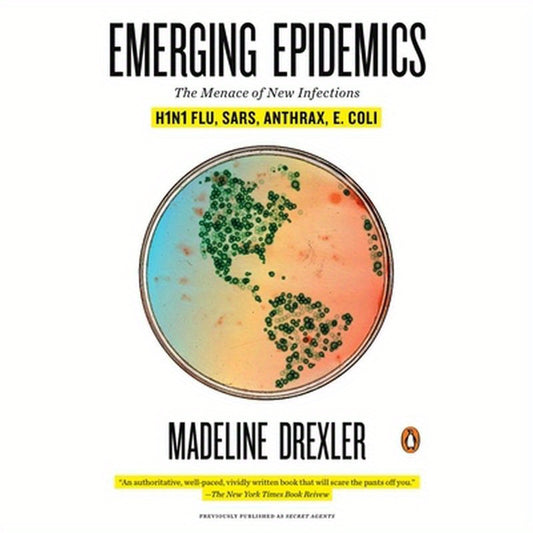
Emerging Epidemics: The Menace of New Infections

Collection: Business, Science and Technology
The triple driving force shaping the future. Scientific exploration of the unknown and discovery of natural laws; Technology transforms it into powerful tools, reshaping social boundaries; Business drives innovation to the market, solves practical problems, and creates inclusive value. This is the center where we observe this great interaction, from breakthroughs in the laboratory to changes in the market, tracking how ideas that truly change the world are born, grow, and impact everyone.
-
A Year Up: Helping Young Adults Move from Poverty to Professional Careers in a Single Year
Regular price $29.00Regular price -
The Story of Earth: The First 4.5 Billion Years, from Stardust to Living Planet
Regular price $24.00Regular price -
Some of My Best Friends Are Black: The Strange Story of Integration in America
Regular price $29.00Regular price -
Shadow of Night
Regular price $24.00Regular price -
Saving the School: One Woman's Fight for the Kids That Education Reform Left Behind
Regular price $29.00Regular price -
Rabid: A Cultural History of the World's Most Diabolical Virus
Regular price $23.00Regular price -
More Than Freedom: Fighting for Black Citizenship in a White Republic, 1829-1889
Regular price $35.00Regular price -
The Last Lost World: Ice Ages, Human Origins, and the Invention of the Pleistocene
Regular price $29.00Regular price -
The Forest Unseen: A Year's Watch in Nature
Regular price $23.00Regular price -
The Idea Factory: Bell Labs and the Great Age of American Innovation
Regular price $24.00Regular price -
City of Dark Magic
Regular price $35.00Regular price -
The Dead Roam the Earth: True Stories of the Paranormal from Around the World
Regular price $29.00Regular price -
Your Medical Mind: How to Decide What Is Right for You
Regular price $29.00Regular price -
Willpower: Rediscovering the Greatest Human Strength
Regular price $24.00Regular price -
Glass Houses: Privacy, Secrecy, and Cyber Insecurity in a Transparent World
Regular price $29.00Regular price -
The Better Angels of Our Nature: Why Violence Has Declined
Regular price $29.00Regular price -
And Then There's This: How Stories Live and Die in Viral Culture
Regular price $29.00Regular price -
Emerging Epidemics: The Menace of New Infections
Regular price $29.00Regular price -
Odd Man Out: A Year on the Mound with a Minor League Misfit
Regular price $29.00Regular price -
The Once and Future King
Regular price $39.00Regular price -
Exam Ref Az-104 Microsoft Azure Administrator
Regular price $54.99Regular price -
Code: The Hidden Language of Computer Hardware and Software
Regular price $44.99Regular price -
Linux Application Development by Example: The Fundamental APIs
Regular price $64.99Regular price -
Architecture for Flow: Adaptive Systems with Domain-Driven Design, Wardley Mapping, and Team Topologies
Regular price $54.99Regular price